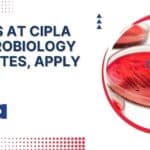
BSc Jobs at Cipla For Microbiology Candidates, Apply Online BSc Jobs at Cipla
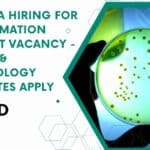
MSD India Hiring For Lab Automation Specialist Vacancy – Biology & Microbiology Candidates Apply MSD India Hiring

Home Search
biology - search results
If you're not happy with the results, please do another search
PerkinElmer MSc/ PhD Biology, Biotechnology Job Opportunity, Apply Online
PerkinElmer Biotech Job, Biology Vacancy - Apply Online
PerkinElmer Biotech Job, Biology Vacancy - Apply Online. MSc, PhD job openings at PerkinElmer. Interested and eligible...
BSc Jobs at Cipla For Microbiology Candidates, Apply Online
BSc Jobs at Cipla For Microbiology Candidates, Apply Online
BSc Jobs at Cipla For Microbiology Candidates, Apply Online. BSc Microbiology Jobs. Interested and eligible applicants...
Syngenta Seeds Junior Scientist Cell Biology Job For MSc Biotech, Apply Online
Syngenta Seeds Job Opening - Junior Scientist Cell Biology Recruitment
Syngenta Seeds Job Opening - Junior Scientist Cell Biology Recruitment. Syngenta Seeds Junior Scientist Cell...
CSIR-CDRI MSc, MTech Life Sciences, Biotech, Biochem, Microbiology Multiple Project Vacancies
CDRI Project Vacancies 2023 For MSc & MTech - Attend Walk-In
CDRI Project Vacancies 2023 For MSc & MTech - Attend Walk-In. CSIR-CDRI Project Vacancies...
DBT Call For Letters of Intent on Cancer Disease Biology, Applications Invited
DBT Call For Letters of Intent on Cancer Disease Biology, Applications Invited
DBT Call For Letters of Intent on Cancer Disease Biology, Applications Invited. Interested...
HCCB Quality Assurance Executive Job Opening For Microbiology, Apply Online
HCCB Quality Assurance Executive Job Opening For Microbiology, Apply Online
HCCB Quality Assurance Executive Job Opening For Microbiology, Apply Online. Hindustan Coca-Cola Beverages Pvt. Ltd....
CSIR-NCL MSc Life Sciences, Biotech, Biochem & Microbiology Project Job – NON-NET Can Also...
NCL Project Vacancy 2023 For MSc Life Sciences Apply Online
NCL Project Vacancy 2023 For MSc Life Sciences Apply Online. NCL Pune is hiring MSc...
BITS Pilani Biology Research Job For MSc, MTech Candidates, Applications Invited
BITS Pilani Biology Research Job For MSc, MTech Candidates, Applications Invited
BITS Pilani Biology Research Job For MSc, MTech Candidates, Applications Invited. MSc, MTech Biology...
Govt ILS MSc Life Sciences, Biochem, Biotech, Microbiology JRF Recruitment
Govt ILS MSc Life Sciences, Biochem, Biotech, Microbiology JRF Recruitment
Govt ILS MSc Life Sciences, Biochem, Biotech, Microbiology JRF Recruitment. MSc Biotech, Biochem, Microbiology, Life...
CSIR-IITR Life, Biological Sciences, Microbiology, Biotech, Biochem, Genetics, Zoology Jobs Available
CSIR-IITR Project Vacancies 2023 For MSc Candidates, Attend Walk-In
CSIR-IITR Project Vacancies 2023 For MSc Candidates, Attend Walk-In. Indian Institute of Toxicology Research (IITR) job...
Tata Medical Center Kolkata MSc Biotech, Microbiology Lab Technician Vacancy Available
TMC Kolkata MSc Biotech, Microbiology Lab Technician Vacancy Available
TMC Kolkata MSc Biotech, Microbiology Lab Technician Vacancy Available. MSc Microbiology and Biotechnology Job at Tata...
Download CSIR NET UNIT 13 Methods In Biology Flowcharts & Mind Maps PDF
CSIR UNIT 13 Flowchart & Mind Maps Download
Biotecnika is a well-known name in the field of life sciences exam preparation. We have been providing...
VIT Vellore MSc Biotech, Microbiology & Life Sciences Project Assistant Openings
VIT Vellore MSc Biotech, Microbiology & Life Sciences Project Assistant Openings
VIT Vellore MSc Biotech, Microbiology & Life Sciences Project Assistant Openings. MSc Microbiology/Biotechnology, Life...
MSD India Hiring For Lab Automation Specialist Vacancy – Biology & Microbiology Candidates Apply
MSD India Hiring For Lab Automation Specialist Vacancy - Biology & Microbiology Candidates Apply
MSD India Hiring For Lab Automation Specialist Vacancy - Biology &...
Illumina Oncology Job Vacancy For MSc, PhD Biology, Cancer Biology, Mol Bio & Mol...
Illumina Oncology Job Vacancy For MSc, PhD Biology, Cancer Biology, Mol Bio & Mol Genetics Candidates
Illumina Oncology Job Vacancy For MSc, PhD Biology, Cancer...